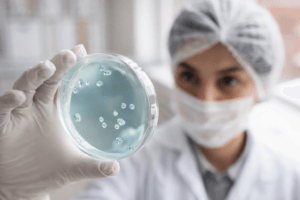

Assessoria na importação de medicamentos para Médicos, Pacientes, Clínicas, Farmácias e Hospitais.
Importar seu medicamento com a Medicsupply é muito seguro, simples e rápido. Não perca mais tempo e contrate nossos serviços agora mesmo.
Assessoria na importação de medicamentos para Médicos, Pacientes, Clínicas, Farmácias e Hospitais.
Importar seu medicamento com a Medicsupply é muito seguro, simples e rápido. Não perca mais tempo e contrate nossos serviços agora mesmo.
Veja como é fácil contratar nossa
Assessoria na Importação de Medicamentos
Importe seu medicamento em 5 passos!
Prescrição
Você só precisa nos enviar a receita médica, escaneada ou fotografada, por e-mail ou WhatsApp, para iniciarmos o processo com agilidade.
1
Solicitação
Entraremos em contato com os nossos fornecedores globais de medicamentos e enviaremos uma cotação para você.
2
Importação
Após a sua confirmação, faremos o pedido e enviaremos os dados para realizar o pagamento com segurança.
3
Transporte
Você receberá o código de rastreio e será atualizado sobre cada etapa do envio por e-mail ou WhatsApp, para acompanhar tudo de forma transparente.
4
Entrega
Acompanhamos o processo até que o medicamento chegue ao seu endereço, garantindo segurança, cuidado e tranquilidade do início ao fim.
5
Primeira Assessoria na Importação de Medicamentos no Brasil
A Medicsupply é pioneira no segmento de assessoria em importação de medicamentos. Há 33 anos, unimos experiência, segurança e compromisso para oferecer um atendimento confiável, ágil e de excelência.
Desde 1992, atuando com responsabilidade para viabilizar tratamentos com segurança.
Atendimento totalmente remoto, facilitando e agilizando todos os trâmites da importação.
Expertise consolidada, garantindo processos eficientes, transparentes e sem complicações para o paciente.
Suporte de segunda a sexta-feira, com equipe especializada pronta para auxiliar.
Logística
A Medicsupply assegura uma logística eficiente para medicamentos importados conforme as solicitações dos fabricantes, oferecendo segurança em todo o processo e rapidez na entrega dos produtos.
1
Infraestrutura
A infraestrutura da nossa empresa foi desenvolvida para oferecer suporte completo, com sistemas modernos e profissionais preparados para atender cada necessidade de cada paciente.
2
Equipe
Contamos com um time especializado em todas as etapas do processo de importação de medicamentos. Nossos profissionais atuam com precisão, responsabilidade e conhecimento técnico, assegurando que cada etapa seja conduzida com segurança, excelência e total atenção às necessidades dos pacientes.
3
Acompanhamento
Oferecemos acompanhamento completo e contínuo de todo o processo de importação, assegurando transparência, agilidade e informações atualizadas para o cliente em cada etapa.
4
Suporte
Disponibilizamos suporte especializado para pacientes, médicos ou hospitais, oferecendo orientações técnicas e esclarecimentos sobre os medicamentos importados, contribuindo para uma assessoria mais segura e bem direcionada.
5
Fornecedores
Trabalhamos há décadas com fornecedores de confiança, todos validados e qualificados pessoalmente pelo nosso setor de qualidade. Garantimos apenas medicamentos idôneos, provenientes de parceiros reconhecidos e certificados, assegurando segurança e autenticidade em cada entrega.
6
Áreas de Atuação
Cardiologia
Acesso a terapias cardiológicas inovadoras do exterior para tratamentos mais modernos e eficazes.

Endocrinologia
Importamos terapias inovadoras para distúrbios endócrinos, trazendo soluções atualizadas do mercado internacional.
Hematologia
Disponibilizamos medicamentos internacionais de última geração para condições hematológicas complexas.
Neurologia
Acesso facilitado a tratamentos neurológicos avançados, desenvolvidos pelos principais centros globais de pesquisa.
Oncologia
Conectamos pacientes a medicamentos oncológicos de ponta, utilizados nos mais renomados protocolos internacionais.
E outras especialidades
Oferecemos acesso a uma ampla variedade de medicamentos inovadores do exterior, sempre conforme a necessidade de cada tratamento.
Só quem é referência consegue alcançar esses números!
A Medicsupply por ser referência no segmento na assessoria de importação de medicamentos, tem orgulho de ter alcançado números tão expressivos e relevantes na área em que atua.
Pacientes Satisfeitos
Clínicas Parceiras
Médicos Prescritores
Hospitais Parceiros
O Futuro da Saúde
Contratar uma assessoria de importação de medicamentos que utiliza tecnologia moderna é importante para garantir agilidade e qualidade no processo de importação.
Registro de Prescrição Médica ONLINE
Processo rápido e sem burocracia para o cadastro do paciente
Gerenciamento de Registro de Pacientes
A utilização de sistemas modernos e tecnologia avançada permite realizar o processo de forma rápida, eficiente e segura
Acompanhamento na Importação de ponta a ponta
Comunicação constante sobre o andamento da importação
Veja o que nossos clientes falam sobre nós
Veja o que nossos clientes dizem sobre a qualidade da nossa assessoria de importação de medicamentos.
EXCELENTE Com base em 185 avaliações Publicado em Rita de Cássia Garcia04/02/2026Trustindex verifica se a fonte original da avaliação é Google. Fui muito bem atendida pela Emanuelle! Chegou no prazo certo, recomendo !Publicado em Renato H30/01/2026Trustindex verifica se a fonte original da avaliação é Google. Muito satisfeito. Superou minhas expectativas. Foi prático, recebi o produto importado da Inglaterra em menos de 20 dias. Precisei apresentar só receita, documento, comprovante de endereço e assinar contrato. Agradeço o serviço prestado.Publicado em Jaine Muniz29/01/2026Trustindex verifica se a fonte original da avaliação é Google. Precisei de um medicamento pra químio e a Emanuelle me atendeu e foi tudo muito prático e rápido o medicamento chegou com menos de 1 mês, todos muito atenciosos e atendimento ágioPublicado em Lara Castro29/01/2026Trustindex verifica se a fonte original da avaliação é Google. Desde o primeiro contato até o recebimento da medicação recebi um atendimento exemplar da Consultora Kátia. Me passou muita confiança e segurança ao realizar a compra.Publicado em Ana Luiza de Souza28/01/2026Trustindex verifica se a fonte original da avaliação é Google. Ótimo atendimento. Precisei de um medicamento para meu filho. Mto atenciosos desde o início do atendimento. Chegou bem rápido.Publicado em Edimar Pereira dos Santos Santos22/01/2026Trustindex verifica se a fonte original da avaliação é Google. Superou minhas expectativas em tudo principalmente na clareza das informações e o acompanhamento monitorado desde a exportação à entrega em tempo recordePublicado em Marcia Moretti16/01/2026Trustindex verifica se a fonte original da avaliação é Google. Agradeço o pronto atendimento na busca e importação da medicação que necessito por estar em falta na farmácia de alto custo e não poder interromper ( teriflunomida para Esclerose Multipla ). Atendimento, atenção, apoio , alem do seguimento e transparência em todo o processo de importação. Parabéns a toda a equipe. Márcia MorettiPublicado em Rafaela Matheus15/01/2026Trustindex verifica se a fonte original da avaliação é Google. Serviço de excelência, pedi um medicamento pra um exame super importante, o prazo era pra 10 dias úteis e chegou em 4, eles tiram todas as dúvidas e as atendentes são bem atenciosas, indico de olhos fechados!Publicado em Milton Acevedo13/01/2026Trustindex verifica se a fonte original da avaliação é Google. Importei Bosentana 125mg com o apoio da Medicsupply. Ótimo atendimento!Certificado: TrustindexO selo verificado do Trustindex é o Símbolo Universal de Confiança. Apenas as melhores empresas podem obter o selo verificado que tem uma pontuação de avaliação acima de 4.5, com base nas avaliações dos clientes nos últimos 12 meses. Leia mais
Confira os conteúdos exclusivos do nosso blog

FDA aprova droxidopa para tratamento da hipotensão ortostática neurogênica
Medicamento é liberado sob aprovação acelerada após anos de avaliação regulatória A Food and Drug Administration dos Estados Unidos aprovou a droxidopa para o tratamento
FDA aprova Avycaz para tratar infecções bacterianas graves
Nova alternativa terapêutica contra bactérias resistentes A Food and Drug Administration anunciou a aprovação do Avycaz, uma nova medicação antibacteriana indicada para adultos com infecções

Melhorando o humor e a ansiedade: o papel da cariprazina no TDM
Evidências indicam benefício no manejo da ansiedade residual em pacientes que não respondem plenamente aos antidepressivos O transtorno depressivo maior (TDM) frequentemente se apresenta associado

Comprimido de budesonida mostra potencial em casos refratários de esofagite eosinofílica
Estudo suíço indica melhora histológica relevante após mudança terapêutica Pacientes com esofagite eosinofílica, uma condição inflamatória crônica caracterizada pelo acúmulo persistente de eosinófilos no

Neuraxpharm amplia opções de tratamento para TDAH na Europa
Novos medicamentos ampliam alternativas terapêuticas para TDAH O tratamento do transtorno de déficit de atenção e hiperatividade (TDAH) em crianças e adolescentes passou a contar

Alterações hormonais em idosos: panorama da nova declaração da Endocrine Society
Documento científico revisa evidências atuais sobre envelhecimento endócrino O envelhecimento populacional tem ampliado o interesse científico sobre como as mudanças hormonais impactam a saúde dos
